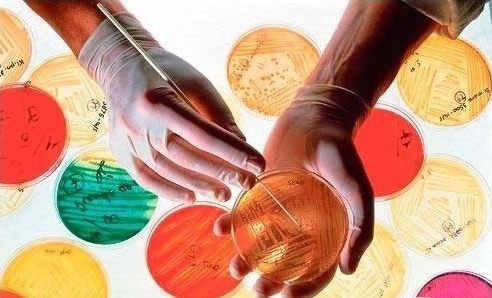

В международном конкурсе «GxP-Профи» участвуют ведущие фармпредприятия России и стран Евразийского экономического союза. Компании не только представляют свои инновационные проекты, но и оказывают экспертную поддержку. К примеру, в рамках выставки Pharmtech & Ingredients 2025, где состоялась сессия, посвященная лучшим проектам конкурса, партнером впервые выступила компания «БиоМерье Рус». Почему международная компания решила поддержать конкурс и какова роль инновационных подходов в обеспечении микробиологического контроля — об этом рассказал Илья Голубев, менеджер по работе с ключевыми клиентами фармацевтического направления компании.
Масштабы конкурса «GxP-Профи» ежегодно растут, к нему присоединяются международные компании. В чем вы видите его привлекательность?
«GxP-Профи» привлекает компании, прежде всего, своей прикладной направленностью. Здесь оцениваются не идеи ради идей, а решения, которые уже внедрены и дали измеримый результат. Для отрасли это крайне важно: компании получают возможность показать реальный эффект от своих инициатив, а коллеги — перенять проверенные практики. Кроме того, конкурс формирует профессиональную среду, где инновации в области качества обсуждаются открыто и на высоком экспертном уровне. Уверен, что в следующем году мы обязательно станем участником «GxP-Профи 2026», хотелось бы поделиться своим инновационными наработками в области лабораторной диагностики.
Конкурс наглядно отражает тренды развития системы качества, в том числе лабораторных практик. Вы работаете над инновациями в области микробиологии, следите за динамикой конкурсных работ. Каковы ваши прогнозы относительно основных тенденций развития микробиологических лабораторий?
Главное — осознанный, риск-ориентированный подход, о котором много говорилось в проектах финалистов «GxP-Профи 2025». Ключевая задача — помочь лабораториям снизить совокупные риски и повысить воспроизводимость результатов. В микробиологическом контроле это особенно критично, поскольку процесс напрямую связан с человеческим фактором и сложными многоэтапными операциями.
Дело в том, что за кажущимся простым выбором «дешево или дорого» на самом деле стоит вопрос управления рисками. Самостоятельное приготовление питательных сред — это многоступенчатый процесс с высокой долей человеческого фактора: навеска, pH, стерилизация, розлив. Любая ошибка на этом пути влияет на достоверность результатов микробиологического мониторинга. Готовые коммерческие среды, напротив, поставляются с гарантированными параметрами и полным пакетом валидационной документации. Это позволяет предприятиям сосредоточиться на контроле процесса, а не на постоянной проверке инструмента.
Если сравнивать только стоимость закупки, то собственное приготовление выглядит дешевле. Но если смотреть комплексно, то есть с учетом валидаций, персонала, оборудования, занимаемых площадей, рисков контаминации и повторных испытаний, картина меняется. Использование коммерческих сред позволяет перераспределить ресурсы лаборатории, снизить нагрузку на персонал и обеспечить стабильность качества, что в итоге соответствует требованиям GMP и стратегическим целям предприятия.
При этом речь не идет о полном отказе от средоварения. Важно соблюдать баланс. Для процессов микробиологического мониторинга, как наиболее массовых и критичных, коммерческие среды уже доказали свою эффективность. Но есть специфические исследования, небольшие объемы, короткие сроки годности — там собственное приготовление может быть оправдано.
Какие рекомендации вы могли бы дать микробиологическим лабораториям предприятий, которые находятся на этапе запуска или модернизации?
Прежде всего, важно проектировать лабораторию с учетом будущего роста производства, а не только текущих задач. Необходимо заранее оценивать потенциальное увеличение объемов мониторинга, нагрузку на персонал и возможности автоматизации. Также стоит рассматривать готовые коммерческие решения как инструмент оптимизации — не только затрат, но также времени и качества данных. Такой подход позволяет выстроить устойчивую систему микробиологического контроля, соответствующую требованиям GMP и готовую к дальнейшему развитию.